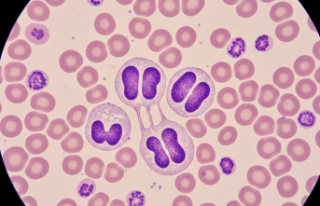
Kan Tetkiklerinde Şaşırtan Bulgular: Pelger Huet...

Nadir Görülen Genetik Hastalık: May Hegglin Anomalisi Nedir?
Kalıtımsal geçiş gösteren ve nadir rastlanan May Hegglin Anomalisi, son dönemde hematoloji kliniklerinde daha sık gündeme gelmeye başladı. Otozomal baskın bir genetik bozukluk olan bu durum, kanda trombosit (kan pulcuğu) sayısının düşük olmasıyla karakterize ediliyor. Hastalığın temelinde MYH9 genindeki mutasyonlar yatıyor. Laboratuvar tetkiklerinde dev trombositlerin görülmesi tanı sürecinde en belirgin ipucu olarak kabul edilmekte.
Vücutta morarma ve diş eti kanaması gibi belirtilerle kendini gösteren bu anomali, çoğu zaman tesadüfen saptanıyor. Hastanenin koridorunda bekleyen ailelerin yüzündeki o belirsiz ifadeyi görünce mesleğin zorluğunu bir kez daha anladım. Birçok hasta hayatı boyunca ciddi bir kanama sorunu yaşamadan rutin hayatına devam edebiliyor. Uzmanlar lökosit (beyaz kan hücresi) içinde yer alan Döhle benzeri inklüzyon cisimciklerinin varlığına dikkat çekiyor. Yapılan son araştırmalara göre vakaların %81'inde bu cisimcikler net olarak gözlemlenirken, bazen bu oran %83 seviyelerine çıkabiliyor.
Tanı konulmıstır aşamasında periferik yayma (kanın lama yayılarak incelenmesi) testi hayati önem taşıyor. Eğer aile geçmişinde benzer kanama bozuklukları varsa genetik tarama yapılması önerilmekte. Tedavi süreci genellikle cerrahi müdahale veya doğum gibi riskli anlarda trombosit desteği sağlanması şeklinde ilerliyor. Rutin kontroller sırasında yapılan muayne ve testler hastanın yaşam kalitesini korumasını sağlar. Belirtiler bazen başka hastalıklarla karıştırılabilir ancak bu durumun tedavisi mümkündür.
Şiddetli kanama riskine karşı hastaların bilinçli olması gerekiyor. Doğru teşhis konulması gereksiz ilaç kullanımının önüne geçmektedir. Tıbbi literatürde bu vakaların takibi büyük titizlik gerektirir. Erken teşhis hayat kurtarır. Genetik danışmanlık almak gelecek nesiller için kritik bir adım olabilir. Hafif kaygı veren bu süreçte modern tıp yöntemleri hastalar için büyük bir umut kaynağı oluşturuyor.
Trombosit: Kanın pıhtılaşmasını sağlayan hücre parçacıkları. Lökosit: Vücudu enfeksiyonlara karşı koruyan bağışıklık hücreleri. İnklüzyon Cisimciği: Hücre sitoplazmasında görülen anormal yapılar.
May Hegglin belirtileri nelerdir https://www.google.com/search?q=site%3Amedihaber.com+May+Hegglin+belirtileri May Hegglin genetik testi https://www.google.com/search?q=site%3Amedihaber.com+May+Hegglin+genetik May Hegglin tedavisi nasıl yapılır https://www.google.com/search?q=site%3Amedihaber.com+May+Hegglin+tedavisi https://www.youtube.com/channel/UCtX2N6269YpWG8bi6qEnMyQ/search?query=May-Hegglin
Gelişmeleri medihaber.com’u ve sosyal medya hesaplarını takip ederek güncel bilgilere ulaşabilirsiniz.